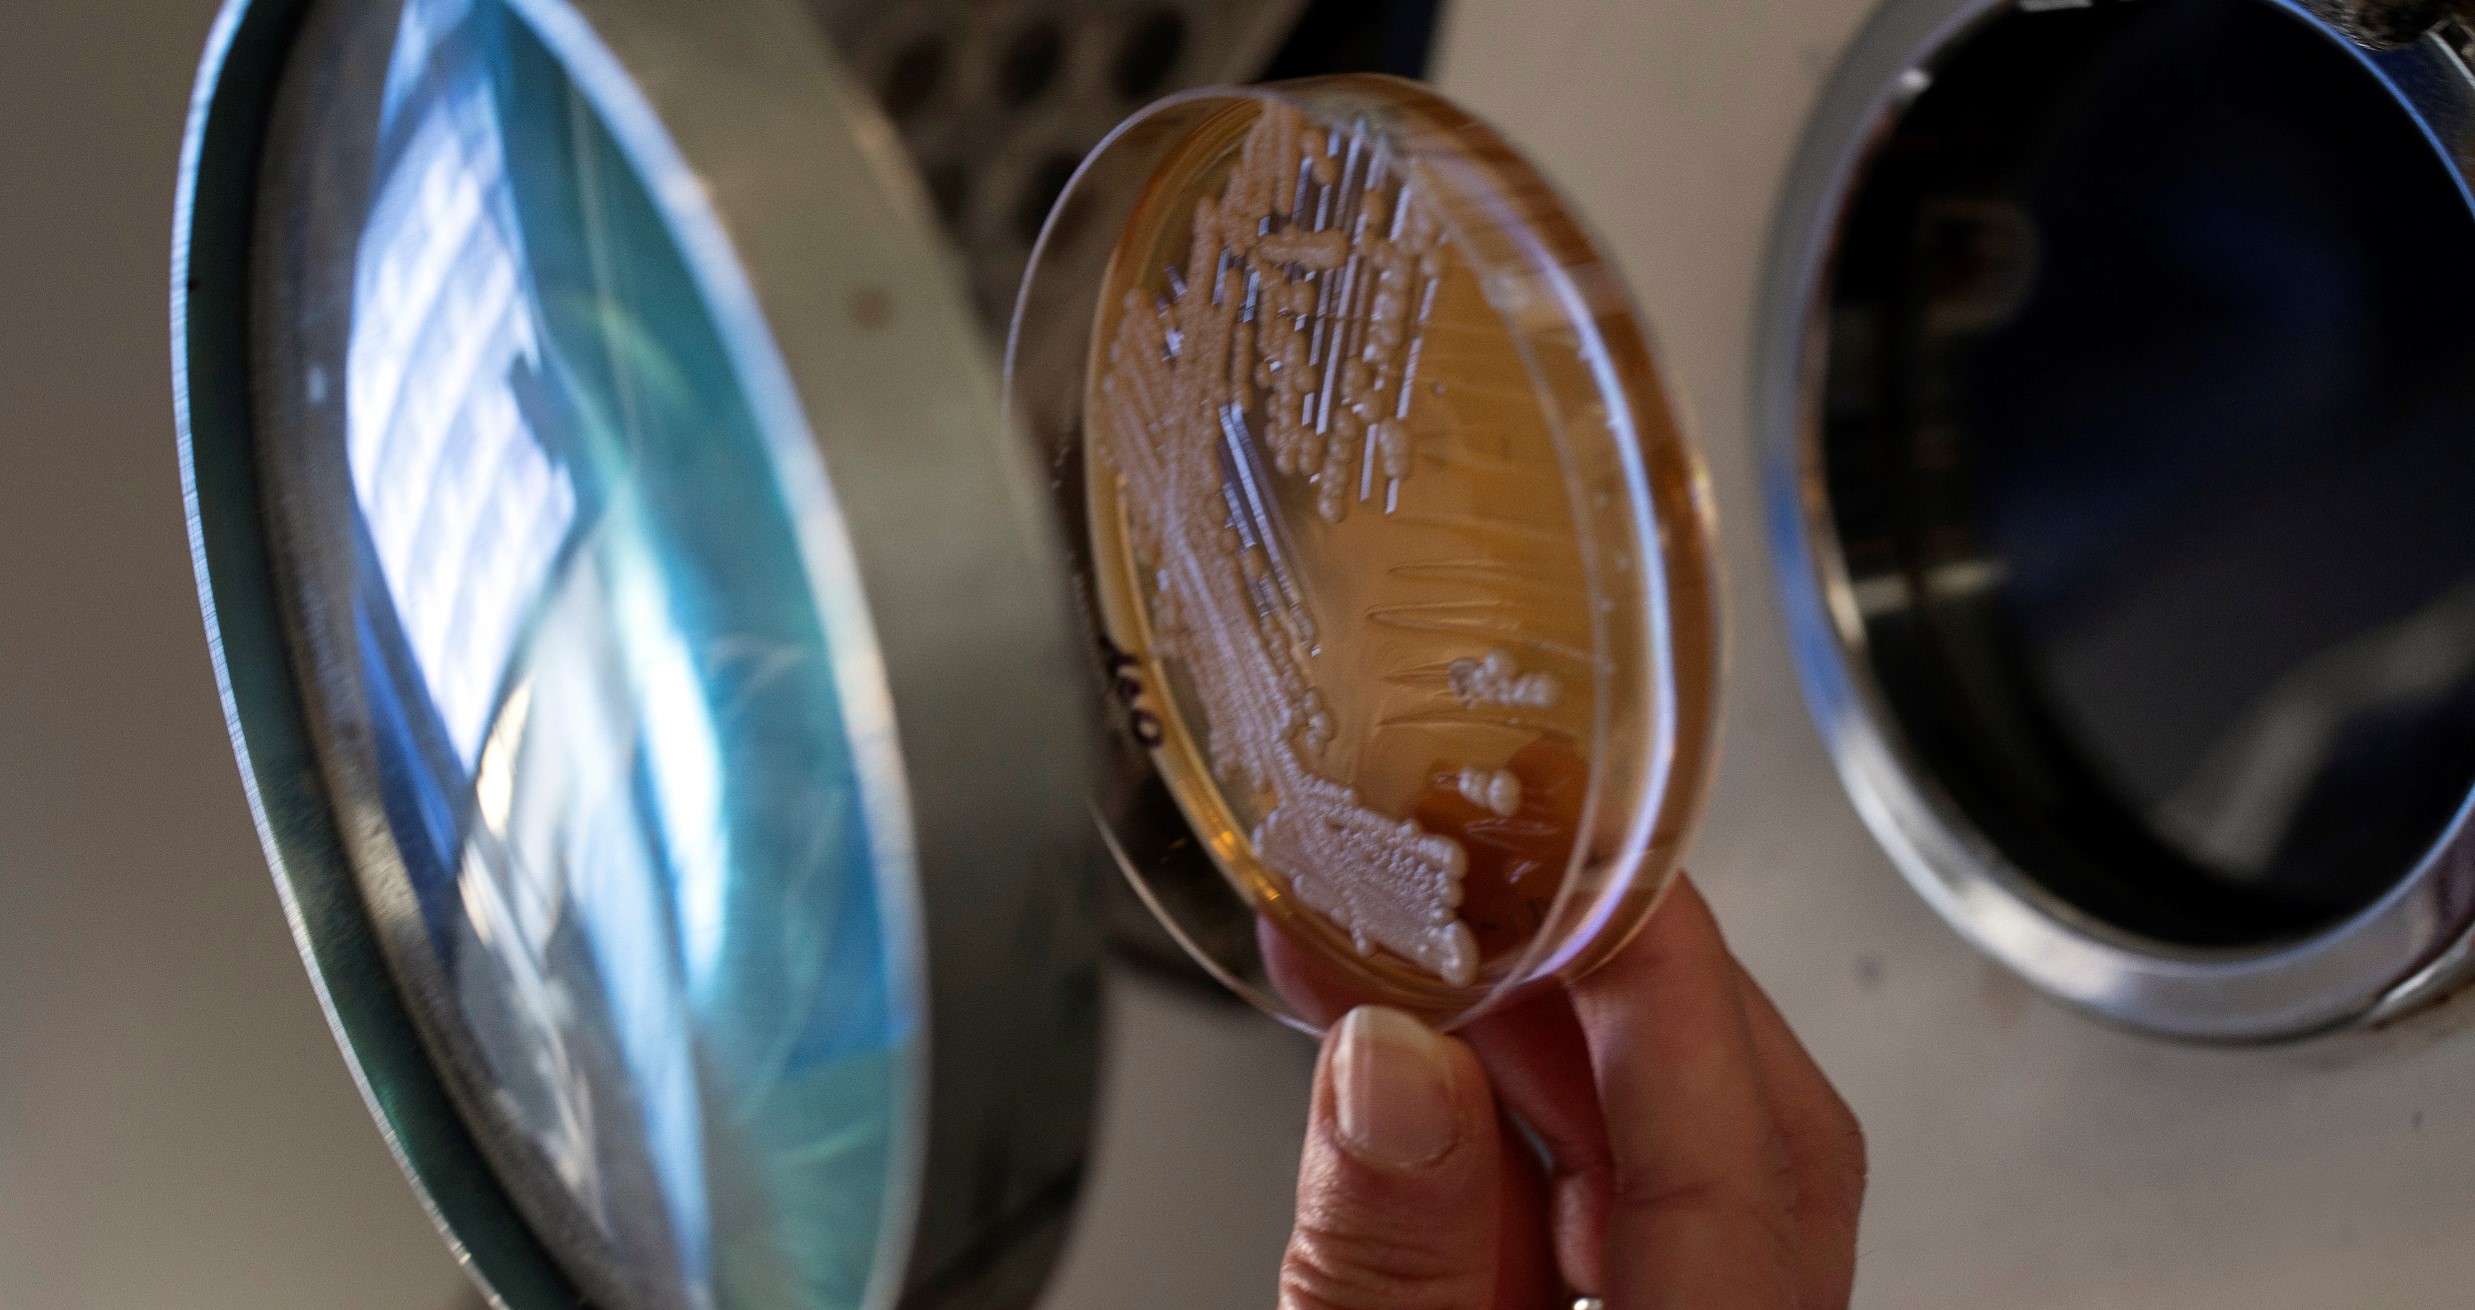

In This Section
- Home
- Study Microbiology at UCC
- Postgraduate Research Programmes
- About
- Research
- People
- Academic Staff
- David Clarke, Head of School
- Hilary Browne
- Marcus Claesson
- Sinéad Corr
- Alan Dobson
- Gerald F. Fitzgerald
- Cormac Gahan
- Colin Hill
- John MacSharry
- Jennifer Mahony
- Ruth Massey
- John P. Morrissey
- Fergal O'Gara
- Niall O'Leary
- Liam O'Mahony
- Paul O'Toole
- Michael B. Prentice
- Gaurav Rajauria
- F. Jerry Reen
- Paul Ross
- Francisco Vitor Santos da Silva
- Martina Scallan
- Pauline Scanlan
- Andrey Shkoporov
- Douwe van Sinderen
- Jens Walter
- Technical Staff
- Administrative Staff
- Academic Staff
- Staff Resources
- Postgrad and Post Doc Committees
- School Seminars
- News/Newsletters
- Athena SWAN
- Current Vacancies
- Contact Us
About The School
Our mission is to perform leading-edge research in the discipline of Microbiology and to train graduates for productive and rewarding scientific careers.
The School of Microbiology in UCC can trace its history to the 1924 appointment of Michael Grimes as the first Agricultural Bacteriologist in UCC who subsequently became the first holder of Chair/Professorship of Dairy Bacteriology, a position that was created in 1940. The Department of Dairy Bacteriology became an independent operational unit at that time, and has evolved into the present day School of Microbiology via a change of title from Department of Dairy and Food Microbiology (between 1960-1995), to Department of Microbiology in 1995, and, finally, to School of Microbiology in 2013. Until the end of the 1960s, the school provided microbiology courses for the Dairy Science programme in the Faculty of Dairy Science. In 1968, the school began to also provide courses in Microbiology to Science students including the BSc (General) Microbiology. In 1970-71, it developed its own Honours programme in Microbiology. This strategic development was to prove an essential element in the evolution of the school into a dynamic, research-orientated entity.
The School of Microbiology UCC now contributes to internationally recognised teaching and research programmes at both undergraduate and postgraduate levels across two of the four Colleges in UCC namely the College of Science, Engineering and Food Science (SEFS) and the College of Medicine and Health. Key sub disciplines, such as medical microbiology, food microbiology, environmental and industrial microbiology are reflected in the programmes. In addition, the rapidly evolving fields of Immunology, Molecular Cell Biology, Environmental Microbial Biotechnology, Molecular Microbial Ecology, Genetic Engineering, Microbe Host Interactions, Cell Signaling, Systems Microbiology, Bioinformatics, Genomics, Pathogenicity, Probiotics and Food & Health are integral to the teaching and research activities of the school.
The research of the school is very prominent at major research conferences, in the form of oral and poster communications, and staff members are consistently invited to give the plenary lectures at these conferences. Up to 100 research publications in international peer reviewed journals are produced each year by staff in the school. This healthy state of research in the school is also indicated by the research income of about €8 million per annum.
Genomics is now centre-stage in Biological Science. The complete sequencing of the human genome and the genomes of several microorganisms and the development of gene array technology, together with developments in protein engineering and methodology to measure cellular reactions in situ, has made the complete understanding of the molecular functioning of cells within the grasp of research scientists in Biology in general, and Microbiologists in particular. The School of Microbiology at UCC plans to strengthen its participation in these exciting developments. The impact of technologies such as gene array technology is not confined to a fundamental understanding of cellular molecular biology, but also strongly impacts on several other areas of fundamental interest to the school such as: responses to environmental ecological signals, gene expression in pathogenesis, virus-host interactions and immunological interactions.
Molecular Biology techniques are making a significant impact in the area of environmental/ecological microbiology. The technology is routinely used to identify the microorganisms in the environment and to examine the physiological basis of the relationships shared by microorganisms and between microorganisms and other inhabitants of many natural environments. Exciting details on signalling between organisms are being uncovered. The School of Microbiology UCC is making a significant contribution to research in this area. There are very practical impacts of work in this area, such as the construction of biological control agents and microbial agents, which will function in waste management, bioremediation and as probiotics.

School of Microbiology
Scoil na Micribhitheolaíochta
Contact us
Microbiology Office, Room FSB452, 4th Floor Food Science & Technology Building, University College Cork, Cork T12 Y337
